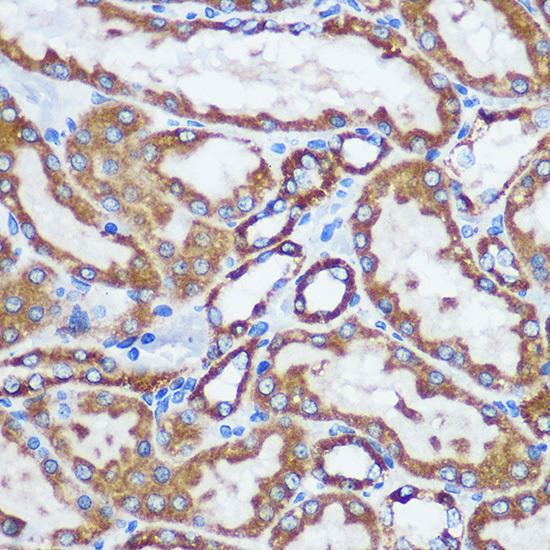
TOM20 Antibody - Human,Mouse,Rat | Assay Genie

マイストア
変更
お店で受け取る
(送料無料)
配送する
納期目安:
2026.01.17 5:17頃のお届け予定です。
決済方法が、クレジット、代金引換の場合に限ります。その他の決済方法の場合はこちらをご確認ください。
※土・日・祝日の注文の場合や在庫状況によって、商品のお届けにお時間をいただく場合がございます。
20.tomomo様 TAKARA TOMY Tomica No.13 Nissan Fairlady Z NISMO GT500 BOX 188704の詳細情報
TAKARA TOMY Tomica No.13 Nissan Fairlady Z NISMO GT500 BOX 188704。Kyosho Mini-Z Auto Scale Collection ASC Woodone Tom's Supra 2004。Endogenous TOM20 Proximity Labeling: A Swiss-Knife for the Study。☆直接注文などあった方は、おまとめに入れ損なっている場合があります(」°ロ°)」その場合こちらにコメントお願いします(`-д-;)ゞおまとめで抜けている場所があればコメントお願いします!☆この度は発送までにお時間を沢山頂きありがとうございました。ルイパパさん苗 ルイママさん苗 中里リンゼアナ 札付き。メルカリ便はサイズによって価格が変わりますので返金して価格一律してます。ファームパルク チリピンキー 茜小鶴 新作2点セット 札付き エケベリア 多肉。死着保証、返金代替え苗などはございません*****************************注☆法改正に伴い、農林水産省に3月26日に屋号をお伝えした上で確認済みの元、説明文を書いております。多*ヤ様 青典牡丹 抜き苗。但し、登録は韓国語は認められておりません。おらいさん苗ミックスベリア 002そわそわ【札付き】。登録がない場合は食用ではなく、観賞用であれば記載は不要ですので今まで通り説明文には記載致しません。ぽぽページ多肉植物12個セット。安心してお買い求め下さい。webp-768.webp。3日以内の決済をお願いします!今回の販売苗は価格や苗の大きさに合わせ送料の変更を行っております。説明文記載通りメルカリ便¥900頂きます。t*m様 【バニラココ】エケベリア 自家繁殖 実生 ホーリンゼ逆交配 ☆希少。希少 優木園さん苗 ザラゴーサSPノバ 札付き 多肉植物 原種。月曜日は完全店休日です発送は皆様の出品と仕分けが終わってからになります♡お支払い期限おまとめ出してから3日以内にお願いします。発送に取り掛かり出しましたら室内管理します!なるべく早い方が苗の変化は少ないですよ(*′艸` ★発送迄に苗に不調がありましたらご連絡しますのでその際は一度キャンセルをしておまとめしなおすか、今現在ハウス内にあります同価格の苗とのチェンジをしていただく形になりますので、その際は必ずご連絡させて頂きますね。じゅーの様 リクエスト 5点 まとめ商品。茜小鶴 札付きポットごとメルカリ便ファームパルクさん苗。種苗登録をされている苗に関しまして、販売は問題ございません。韓国で作られた苗でも韓国の方が日本での登録も出来ますので、韓国苗であろうと関係ないわけではございません。ま**様 【バニラココ】エケベリア 自家繁殖 実生 ホーリンゼ逆交配 ☆希少。ファームパルクさん苗新作命名株 No.12茜小鶴。日本での登録は日本語、ローマ字のみ登録出来ます。販売する苗の名前を全て確認をした上で販売しております。専用 超希少 おらいさん苗 ザラゴーサSPノバ 札付き 子株付き 多肉植物。Yu...@様 4点おまとめ。(種苗登録は、個人が販売する事から販売店園芸店を守る観点、そして生産農家を守ると言う意味もあります。)屋号 Merry project佐賀県農業者登録有り事業所登録、農業者登録しております。***様 青鬼 ミックスベリア おらいさん苗 多肉植物 エケベリア。97.【札付き】エレガンス ラパス ヴォン ベッキオ 多肉植物 エケベリア原種。
ベストセラーランキングです
近くの売り場の商品
カスタマーレビュー
オススメ度 4.1点
現在、6071件のレビューが投稿されています。